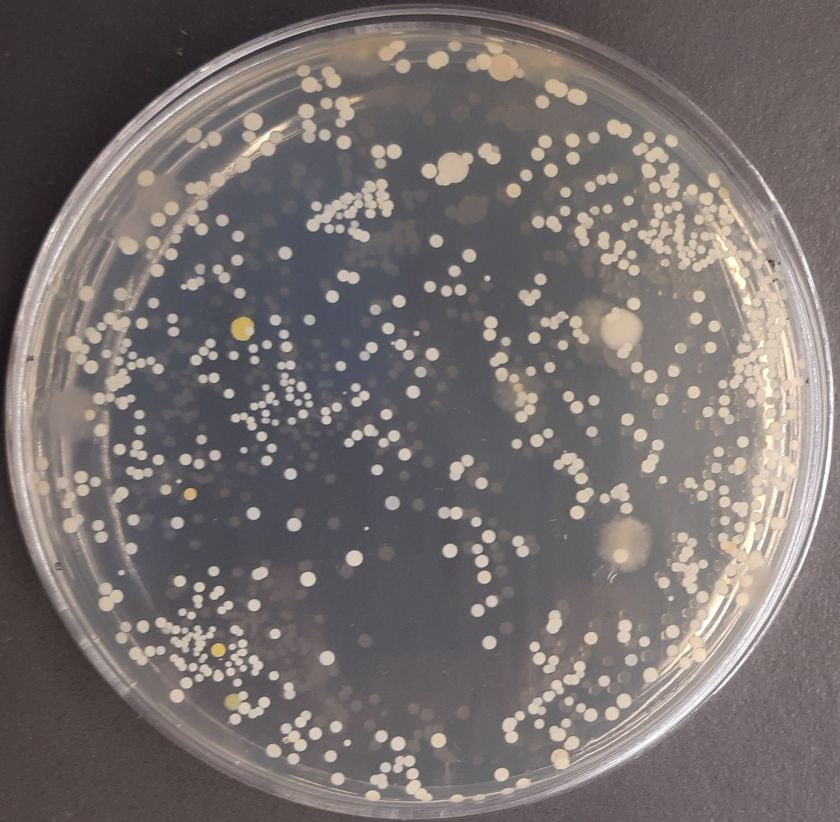

Tai, jog pinigai, durų rankenos, lifto mygtukai, kompiuterio, bankomato klaviatūra ir kiti daiktai, kuriuos liečia daugelis žmonių, gali būti infekcijos židiniu – anokia naujiena. Tačiau neseniai Lietuvoje atliktas tyrimas parodė, kad nemažiau mikrobų knibžda ir ant paštomatų, o tiksliau jų ekranų, paviršiaus. Artėjant bene intensyviausiam šventiniam, o tuo pačiu ir pirkimų laikotarpiui, patariama atidžiai rinktis ne tik paštomatus, bet ir nepamiršti apie rankų dezinfekciją ar kitas papildomas saugos priemones. Bakterijos aptiktos ant visų liečiamų paštomatų paviršių Viso tyrimo metu buvo ištirta 11-os paštomatų, esančių skirtingose sostinės vietose, paviršiai. Paimtų mėginių rezultatai, pasak VU Gyvybės mokslų centro tyrėjos dr. Renatos Gudiukaitės nestebina, kadangi visi šie paštomatai lokalizuoti didelius žmonių srautus pritraukiančiuose prekybos centruose…
Inžinerijos studijų klasterio įmonių stipendijos – VDU ŽŪA pirmakursiams
Penki VDU Žemės ūkio akademijos Inžinerijos fakulteto studijų programos „Žemės ūkio mechanikos inžinerija” pirmakursiai visus šiuos mokslo metus džiaugsis kiekvieną mėnesį gaunamomis 100 Eur dydžio stipendijomis. Vaikinų teigimu, agroverslo įmonių skirtos stipendijos – netikėta, džiugu bei skatina nenukrypti nuo užsibrėžto tikslo. Stipendijų steigėjos – į pirmąjį Lietuvoje Žemės ūkio inžinerijos studijų klasterį, skirtą inžinerijos studijų krypties programų įgyvendinimui bei inovatyvių ir įtraukių mokymo formų diegimui, susibūrusios agroverslo įmonės AB „Lytagra”, UAB „Baltic Agro Machinery”, UAB „Agrokoncernas”, UAB „Dojus agro”, UAB „Dotnuva Baltic”, pastaruoju metu itin stokojančios šiuolaikišką inžinerinį išsilavinimą įgijusių jaunų specialistų. Mokytis akademijoje – prestižas Iš Panevėžio rajono kilęs UAB „Baltic Agro Machinery” stipendininkas Dovydas Mikulskis teigia, kad žemės…
Pradėjo veikti išskirtinis sveikatos centras: sergantiesiems nutukimu ir diabetu – naujo tipo paslaugos
Kaune pradeda veikti specializuotas sveikatos centras, skirtas nutukimu, cukriniu diabetu ir kitomis susijusiomis lėtinėmis ligomis sergantiems pacientams. Naujojo sveikatos centro veiklos principas – kitoks nei įprastai. Jame nevyks vienkartinių gydytojų specialistų konsultacijų, bet pacientams bus teikiamos ilgalaikės kompleksinės sveikatos priežiūros ir sveikatinimo paslaugos, atsižvelgiant į individualius jų poreikius. Su pacientais centre dirbs visa specialistų komanda: suaugusiųjų ir vaikų gydytojai endokrinologai, kardiologai, oftalmologai, slaugytojos-diabetologės, medicinos psichologai, gyvensenos medicinos, fizinio aktyvumo specialistai, ergoterapeutai. Diabetu ir kitomis susijusiomis ligomis sergantiems asmenims bus teikiamos individualios konsultacijos, mažose grupėse vyks kompleksinės sveikatinimo programos. Naujasis sveikatos centras pavadintas Oskaro Minkovskio vardu, pagerbiant žymų daugiau nei prieš 100 metų Kaune gimusį gydytoją ir mokslininką, vieną iškiliausių to…
RRT apklausa rodo, kad dauguma vartotojų patenkinti gaunamomis elektroninių ryšių paslaugomis
Lietuvos Respublikos ryšių reguliavimo tarnybos (RRT) atlikta naujausia elektroninių ryšių paslaugų vartotojų apklausa parodė, kad didžioji dauguma respondentų (91 proc.) naudojasi mobiliuoju telefono ryšiu. Fiksuotojo ryšio telefono paslaugomis naudojasi tik 14 proc. apklaustųjų, šios paslaugos labiausiai aktualios vyresniems nei 65 metų ne miesto gyventojams. Mobiliojo ryšio paslaugomis patenkinti 85 proc., mobiliuoju internetu ̶ 79 proc., fiksuotojo telefono ryšio paslaugomis ̶ 83 proc., o fiksuotojo ryšio internetu ̶ 79 proc. Lietuvos vartotojų. Dažniausia vartotojų nepasitenkinimo šiomis paslaugomis priežastis ̶ per aukštos paslaugų kainos. RRT 2021 m. spalio mėnesį atlikta sociologinė apklausa atskleidė, kad daugiausiai respondentų už fiksuotojo ryšio interneto paslaugas išleidžia nuo 10 iki 15 Eur (43 proc.), už mobiliojo…
Seimo Lietuvos valstiečių ir žaliųjų sąjungos frakcijos pranešimas: frakcija atsakyti į klausimus kviečia Kęstutį Navicką
Lietuvos valstiečių ir žaliųjų sąjungos (LVŽS) frakcija Seime antradienį kviečia žemės ūkio ministrą (ŽŪM) Kęstutį Navicką atsakyti į frakcijos narių klausimus. Frakcijos posėdis rengiamas reaguojant į ūkininkų, žemės ūkio įmonių vadovų, specialistų, maisto pramonės atstovų bei Lietuvos žemės ūkio tarybos skundus, jog K. Navickas nuo pirmųjų darbo dienų kuria dirbtines kliūtis bendradarbiavimui su mokslo ir žemdirbių bendruomene. LVŽS frakcija pabrėžia, kad šiuo metu Europos Sąjungos valstybės narės intensyviai rengia savo strateginius planus, organizuodamos plačias ir skaidrias konsultacijas su ekonominiais ir socialiniais partneriais. Tuo tarpu ŽŪM tik imituoja konsultacijas ir diskusijas su žemdirbių savivalda. „Ministras nereaguoja ne tik į žemdirbių organizacijų, bet ir į savo paties sušauktos visuomeninių patarėjų tarybos narių…
„Orion Leasing“ gavo 30 mln. eurų portfelinę garantiją finansavimui, kurį skirs Lietuvos verslo įmonėms
Europos investicinis fondas (EIF) lizingo verslui bendrovei „Orion Leasing“ skyrė 30 milijonų eurų portfelinę garantiją. Turėdama šią garantiją „Orion Leasing“ bendrovė Lietuvos verslo įmonėms jau gali pasiūlyti geresnes finansavimo sąlygas investicijoms į įvairią įrangą, techniką bei plėtrą. Maksimali vieno lizingo sandorio su portfeline garantija suma gali siekti 1,5 mln. eurų, o trukmė gali siekti 10 metų. „Ši portfelinė garantija yra tikrai puiki galimybė Lietuvos verslui pritraukti lėšų labai geromis sąlygomis. Mums, kaip dar gana jaunai įmonei, tai irgi didžiulis laimėjimas. Gaudami 30 milijonų eurų garantiją, mes galėsime kur kas drąsiau finansuoti įmones, kurios siekia greitos ir efektyvios prieigos prie kapitalo investicijoms į verslo plėtrą, modernizavimą bei technologinį progresą“, – komentuoja…
MRU išreiškia palaikymą demokratijos siekiantiems baltarusiams: dalyvaus solidarumo akcijoje
Mykolo Romerio universitetas (MRU) lapkričio 23 d. dalyvaus vienybės su demokratijos siekiančiais Baltarusijos piliečiais akcijoje. Vilniaus centre, Neries krante prie Žvėryno tilto prieš Lietuvos Respublikos Seimo rūmus, rytoj bus atidaryta „Demokratijos vigilija. Baltarusijos alėja“. Kartu su Lietuvos visuomenės, akademinės bendruomenės, baltarusius vienijančių nevyriausybinių organizacijų atstovais šermukšnių medelius šioje alėjoje sodins MRU rektorė prof. dr. Inga Žalėnienė ir universiteto dėstytojų ir studentų grupė. Baltarusijos alėjos Vilniuje atidarymas išreiškia Lietuvos žmonių paramą demokratijos siekiantiems Baltarusijos piliečiams. Seimo nario Giedriaus Surplio inicijuotos akcijos metu Balatrusijos demokratijos alėjoje bus pasodinta 16 šermukšnių sodinukų. „Akademinė bendruomenė negali likti nuošalyje, kai žmonės imasi atsakomybės dėl savo šalies ateities ir siekia pokyčio. Su giliu susirūpinimu stebime kaimyninės…
Seimo Pirmininkė Prancūzijoje dalyvaus susitikimuose, skirtuose diplomatinių santykių užmezgimo jubiliejui pažymėti
Seimo Pirmininkė Viktorija Čmilytė-Nielsen rytoj su darbo vizitu išvyksta į Paryžių (Prancūzijos Respublika), kur lapkričio 23–25 dienomis kartu su Latvijos Respublikos Saeimos Pirmininke Inara Mūrniece (Ināra Mūrniece) ir Estijos Respublikos Rygikogo Pirmininku Jūriu Ratasu (Jüris Ratas) Prancūzijos Respublikos Nacionalinės Asamblėjos Pirmininko Rišaro Ferano (Richard Ferrand) kvietimu dalyvaus susitikimuose, skirtuose diplomatinių santykių de facto ir de jure užmezgimo 100-mečiams pažymėti. Trijų Baltijos šalių parlamentų pirmininkai susitiks su Prancūzijos Respublikos Senato Pirmininku Žeraru Laršė (Gérard Larcher) ir Prancūzijos Respublikos Nacionalinės Asamblėjos Pirmininku R. Feranu, dalyvaus iškilminguose pietuose Lietuvos, Latvijos, Estijos ir Prancūzijos diplomatinių santykių šimtmečiui paminėti. Vizito metu Seimo Pirmininkė susitiks su Prancūzijos politikais, politologais, apžvalgininkais ir akademikais, Prancūzijos lietuvių bendruomenės nariais.…
Biometaną planuojama išgauti ir Lietuvoje – aplinkai draugiško kuro jėgainė kils prie Panevėžio
Pranešimas žiniasklaidai 2021 lapkričio 22 d. Biometaną planuojama išgauti ir Lietuvoje – aplinkai draugiško kuro jėgainė kils prie Panevėžio Kol kas visas Lietuvoje naudojamas biometanas yra importuojamas iš užsienio šalių tarptautinių sertifikatų keliu ir Lietuvoje negaminamas. Vis dėlto artimiausiais metais situacija turėtų smarkiai pasikeisti – viena pirmųjų biometano dujų gamybos jėgainių iki 2023 m. turėtų iškilti prie Panevėžio, Šilagalyje, netoli magistralės „Via Baltica“. Biometanas bus saugiai gaminamas iš vietos žemės ūkio bendrovės „Šilagalis“ biologiškai skaidžių atliekų – gyvulių mėšlo ir žemės ūkio bei kitų organinės kilmės atliekų. Į jėgainės statybas ir infrastruktūros sutvarkymą planuojama investuoti 4 mln. EUR. Pagamintas biometanas atitiks Atsinaujinančių išteklių energetikos įstatyme numatytus biodegalų tvarumo kriterijus ir…
Šalies vadovas pasveikino perrinktąjį Bulgarijos Prezidentą
Lietuvos Respublikos Prezidentas Gitanas Nausėda pasveikino Rumeną Radevą perrinkimo Bulgarijos Prezidentu proga. „Esu tikras, kad Jūsų antrosios kadencijos metu ir toliau stiprinsime mūsų sėkmingą dvišalį bendradarbiavimą politikos, ekonomikos ir kultūros srityse. Džiaugiuosi, kad sprendžiant reikšmingus saugumo, nelegalios migracijos ir sienų apsaugos klausimus galime pasikliauti Bulgarija kaip patikima partnere Europos Sąjungoje ir sąjungininke NATO. Taip pat esu tikras, kad mūsų valstybių dalyvavimas Trijų jūrų iniciatyvoje prisidės prie transatlantinių ryšių stiprinimo ir spartesnio regioninių iniciatyvų ir projektų įgyvendinimo“, – rašoma Prezidento sveikinime. Šalies vadovas taip pat pabrėžė, kad tik veikdami išvien galime įveikti sudėtingus iššūkius ir užtikrinti mūsų valstybių ir kartu visos Europos Sąjungos tvarų vystymąsi. „Savo ruožtu norėčiau pažymėti, kad Lietuva tvirtai…